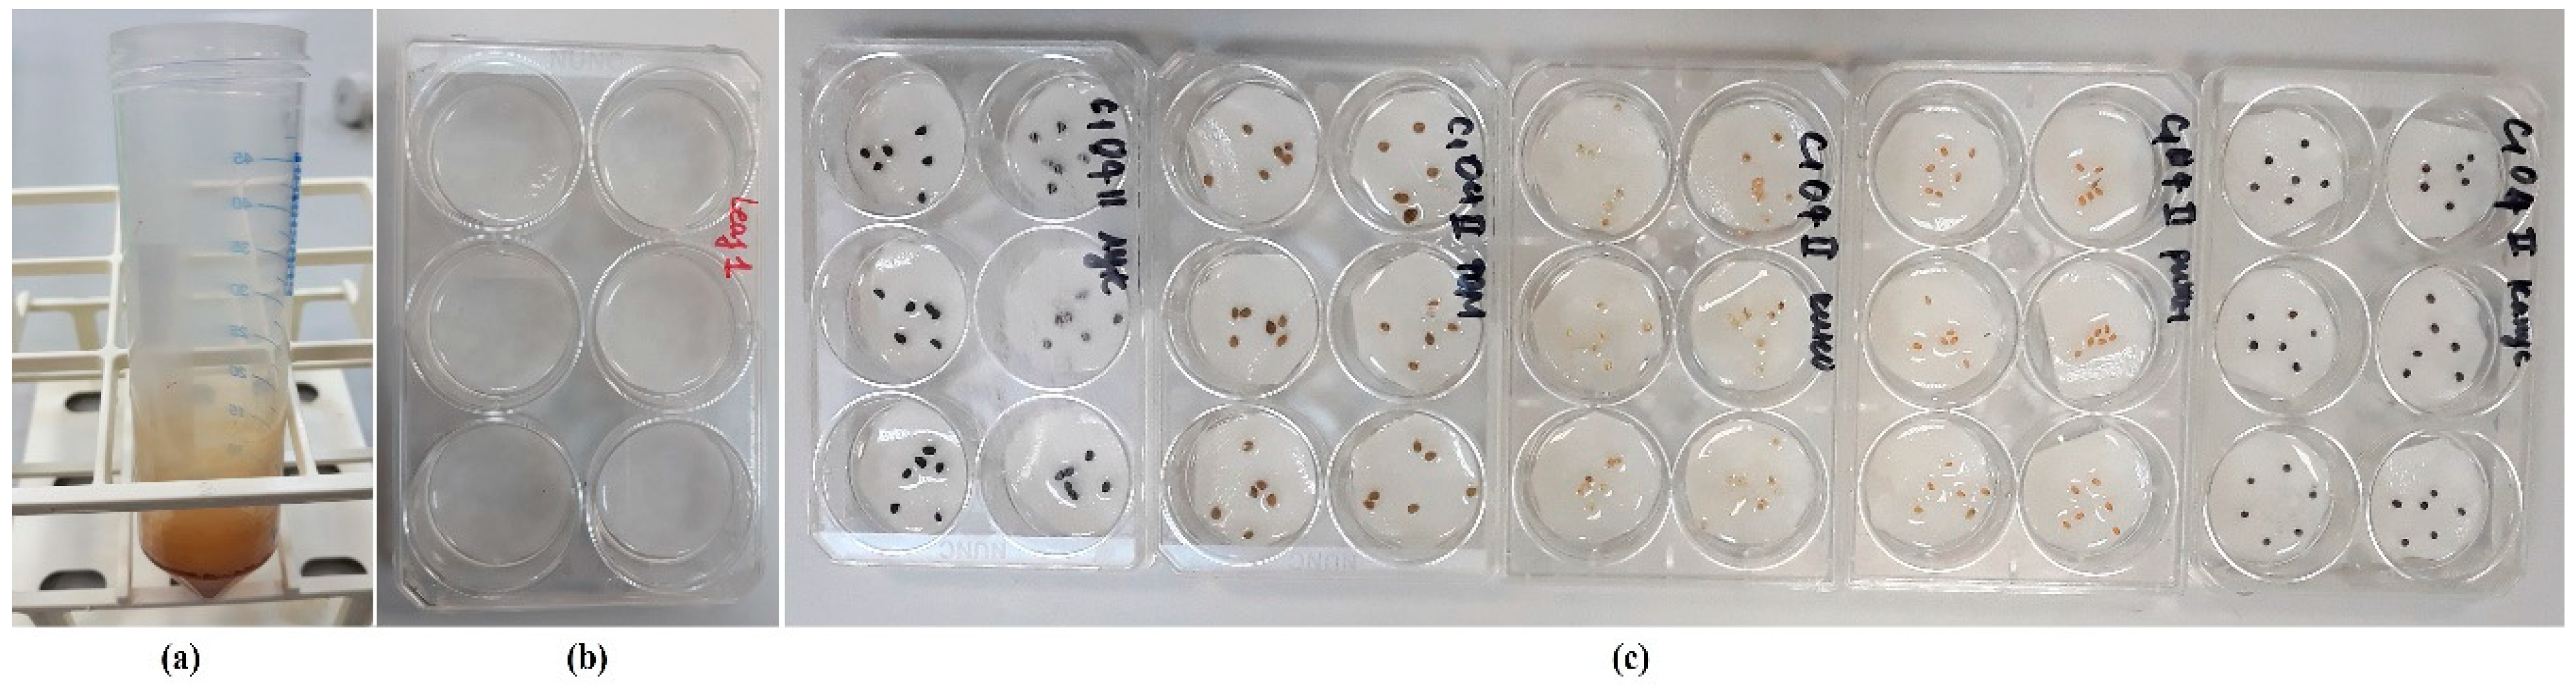
Horticulturae 09 00554 g002 Horticulturae 09 00554 g002

In Vitro Effect of Purple Amomum (Amomum longiligulare T.L. Wu) Extracts on Seed Germination and Seedling Growth of Different Crop Species
Abstract
1. Introduction
2. Materials and Methods
2.1. Plant Material
2.2. Total Content of Phenolic and Flavonoid
2.2.1. Preparation of Extract Solution
2.2.2. Determination of Total Phenolic Content (TPC)
2.2.3. Determination of Total Flavonoid Content (TFC)
2.3. Bioassay to Assess Seed Germination and Seedling Growth of the Five Bio-Indicator Species
2.4. Statistical Processing of Experimental Results
3. Results
3.1. Total Content of Phenolic and Flavonoid
3.2. Effect of Purple Amomum Plant Extracts on Seed Germination of Five Bio-Indicator Species
3.3. Effect of Purple Amomum Plant Extracts on Seedling Growth of Five Bio-Indicator Species
4. Discussion
5. Conclusions
Supplementary Materials
Author Contributions
Funding
Institutional Review Board Statement
Informed Consent Statement
Data Availability Statement
Conflicts of Interest
References
- Peterson, M.A.; Collavo, A.; Ovejero, R.; Shivrain, V.; Walsh, M.J. The challenge of herbicide resistance around the world: A current summary. Pest Manag. Sci. 2018, 74, 2246–2259. [Google Scholar] [CrossRef] [PubMed]
- Moss, S. Integrated weed management (IWM): Why are farmers reluctant to adopt non-chemical alternatives to herbicides? Pest Manag. Sci. 2019, 75, 1205–1211. [Google Scholar] [CrossRef] [PubMed]
- Dayan, F.E.; Cantrell, C.L.; Duke, S.O. Natural products in crop protection. Bioorg. Med. Chem. 2009, 17, 4022–4034. [Google Scholar] [CrossRef] [PubMed]
- Fawad, M.; Khan, M.A.; Wahid, F.; Khan, H.; Gul, B.; Khattak, A.M.; Mastinu, A. Irrigation Scheduling and Weed Management: A Sustainable Approach for Managing Broomrape and Other Weeds in Tomato Crop. Horticulturae 2022, 8, 676. [Google Scholar] [CrossRef]
- Kato-Noguchi, H. Assessment of allelopathic potential of shoot powder of lemon balm. Sci. Hortic. 2003, 97, 419–423. [Google Scholar] [CrossRef]
- Djurdjevic, L.; Dinic, A.; Pavlovic, P.; Mitrovic, M.; Karadzic, B.; Tesevic, V. Allelopathic potential of Allium ursinum L. Biochem. Syst. Ecol. 2004, 32, 533–544. [Google Scholar] [CrossRef]
- Gharibvandi, A.; Karimmojeni, H.; Ehsanzadeh, P.; Rahimmalek, M.; Mastinu, A. Weed management by allelopathic activity of Foeniculum vulgare essential oil. Plant Biosyst. Int. J. Deal. All Asp. Plant Biol. 2022, 156, 1298–1306. [Google Scholar] [CrossRef]
- Islam, A.K.M.; Kato-Noguchi, H. Phytotoxic activity of Ocimum tenuiflorum extracts on germination and seedling growth of different plant species. Sci. World J. 2014, 2014, 676242. [Google Scholar] [CrossRef]
- Fujii, Y.; Parvez, S.S.; Parvez, M.M.; Ohmae, Y.; Iida, O. Screening of 239 medicinal plant species for allelopathic activity using the sandwich method. Weed Biol. Manag. 2003, 3, 233–241. [Google Scholar] [CrossRef]
- Gilani, S.A.; Adnan, S.M.; Shinwari, Z.K.; Fujii, Y.; Kikuchi, A.; Watanabe, K.N. Phytotoxic studies of medicinal plant species of Pakistan. Pak. J. Bot. 2010, 42, 987–996. [Google Scholar]
- Nazir, T.; Uniyal, A.K.; Todaria, N.P. Allelopathic behavior of three medicinal plant species on traditional agriculture crops of Garhwal Himalaya, India. Agrofor. Syst. 2006, 69, 183–187. [Google Scholar] [CrossRef]
- Christenhusz, M.J.; Byng, J.W. The number of known plants species in the world and its annual increase. Phytotaxa 2016, 261, 201–217. [Google Scholar] [CrossRef]
- Han, C.M.; Pan, K.W.; Wu, N.; Wang, J.C.; Li, W. Allelopathic effect of ginger on seed germination and seedling growth of soybean and chive. Sci. Hortic. 2008, 116, 330–336. [Google Scholar] [CrossRef]
- Pukclai, P.; Kato-Noguchi, H. Evaluation of allelopathic potential of Amomum krervanh Pierre ex Gagnep. Am. Eurasian J. Agric. Environ. Sci. 2013, 13, 343–347. [Google Scholar]
- Satyal, P.; Dosoky, N.S.; Kincer, B.L.; Setzer, W.N. Chemical compositions and biological activities of Amomum subulatum essential oils from Nepal. Nat. Prod. Commun. 2012, 7, 1233–1236. [Google Scholar] [CrossRef] [PubMed]
- De Melo, S.C.; De Sa, L.E.C.; De Oliveira, H.L.M.; Trettel, J.R.; da Silva, P.S.; Gonçalves, J.E.; Magalhães, H.M. Chemical constitution and allelopathic effects of Curcuma zedoaria essential oil on lettuce achenes and tomato seeds. Aust. J. Crop Sci. 2017, 11, 906–916. [Google Scholar] [CrossRef]
- Ibanez, M.D.; Blazquez, M.A. Ginger and turmeric essential oils for weed control and food crop protection. Plants 2019, 8, 59. [Google Scholar] [CrossRef]
- Mahanta, B.P.; Kemprai, P.; Bora, P.K.; Lal, M.; Haldar, S. Phytotoxic essential oil from black turmeric (Curcuma caesia Roxb.) rhizome: Screening, efficacy, chemical basis, uptake and mode of transport. Ind. Crops Prod. 2022, 180, 114788. [Google Scholar] [CrossRef]
- Fujita, T.; Nishimura, H.; Kaburagi, K.; Mizutani, J. Plant growth inhibiting α-pyrones from Alpinia speciosa. Phytochemistry 1994, 36, 23–27. [Google Scholar] [CrossRef]
- Mongkol, R.; Chavasiri, W.; Ishida, M.; Matsuda, K.; Morimoto, M. Phytotoxic and antiphytopathogenic compounds from Thai Alpinia galanga (L.) Willd. rhizomes. Weed Biol. Manag. 2015, 15, 87–93. [Google Scholar] [CrossRef]
- Lim, T.K. Amomum longiligulare. In Edible Medicinal and Non-Medicinal Plants; Lim, T.K., Ed.; Springer Publ.: Dordrecht, The Netherlands, 2013; Volume 5, p. 801. [Google Scholar]
- Nguyen, Q.B.; Padua, L.S.; Bunyaprapatsara, N.; Lemmens, R.H.M.J. Amomum is Medicinal and Poisonous Plants. In Plant Resources of South-East Asia; Padua, L.S., Ed.; Backhuys Publ.: Leiden, The Netherlands, 1999; Volume 12. [Google Scholar]
- Do, T.H.V. Study on some non-volatile chemical components and micronutrients of Vietnamese amomum (Amomun longiligulare T.L.Wu.). Ph.D. Thesis, Hanoi University of Science and Technology, Hanoi, Vietnam, 20 March 2001. [Google Scholar]
- Liu, J.P.; Du, Z.Z.; Ye, Y. Separation and Antioxidant Activity of the Chemical Constituents from Eupatorium Fortuneiturcz. and Amomum Longiligulare T.L.Wu. Food Sci. Eng. Zhejiang Technol. Bus. Univ. 2013, 2013, 1–9. [Google Scholar]
- Hao, Y.; Jinpeng, L.; Qizhen, D. Analysis and determination of oestrogen-active compounds in frutus amoni by the combination of highspeed counter-current chromatography and high performance liquid chromatography. J. Chromatogr. B 2014, 954, 36–42. [Google Scholar]
- Chau, L.; Thang, T.D.; Huong, L.T.; Ogunwande, I.A. Constituents of essential oils from Amomum longiligulare T.L. Wu from Vietnam. Chem. Nat. Compd. 2015, 51, 1181. [Google Scholar] [CrossRef]
- Anh, T.T.; Ngoc, N.B.; Phuc, N.D.; Nhat, D.D.; Danh, P.H.; Bach, L.G. Essential oil from Amomum longiligulare T.L. Wu cultivated in Ninh Thuan province, Vietnam. IOP Conf. Ser. Mater. Sci. Eng. 2020, 991, 012113. [Google Scholar] [CrossRef]
- Sabulal, N.; Baby, S. Chemistry of Amomum essential oils. J. Essent. Oil Res. 2021, 33, 427–441. [Google Scholar] [CrossRef]
- Hung, N.; Toan, N.H. Chemical constituents and antibacterial activity of essential oils in Amomum longiligulare from Vietnam. Proc. Appl. Bot. Genet. Breed. 2022, 183, 59–65. [Google Scholar] [CrossRef]
- Chung, I.M.; Ahn, J.K.; Yun, S.J. Identification of allelopathic compounds from rice (Oryza sativa L.) straw and their biological activity. Can. J. Plant Sci. 2001, 81, 815–819. [Google Scholar] [CrossRef]
- Khanh, T.D.; Chung, M.I.; Xuan, T.D.; Tawata, S. The exploitation of crop allelopathy in sustainable agricultural production. J. Agron. Crop Sci. 2005, 191, 172–184. [Google Scholar] [CrossRef]
- Khanh, T.D.; Trung, H.K.; Anh, H.L.; Xuan, D.T. Allelopathy of barnyardgrass (Echinochloa crus-galli) weed: An allelopathic interaction with rice (Oryza sativa). Vietnam. J. Agric. Sci. 2018, 1, 97–116. [Google Scholar]
- Kalashnikova, E.A.; Mironova, O.U.; Lavrova, N.V.; Kochieva, E.Z.; Cherednichenko, M.U.; Karsunkina, N.P.; Kalashnikov, D.V.; Pronina, N.B. Laboratory Workshop on Agricultural Biotechnology, 2nd ed.; Publishing House of the Ministry of Agriculture: Moscow, Russia, 2004; p. 115. [Google Scholar]
- Singh, H.P.; Batish, D.R.; Pandher, J.K.; Kohli, R.K. Phytotoxic effects of Parthenium hysterophorus residues on three Brassica species. Weed Biol. Manag. 2005, 5, 105–109. [Google Scholar] [CrossRef]
- Mahdavikia, F.; Saharkhiz, M.J. Phytotoxic activity of essential oil and water extract of peppermint (Mentha× piperita L. cv. Mitcham). J. Appl. Res. Med. Aromat. Plants 2015, 2, 146–153. [Google Scholar] [CrossRef]
- Khalloufi, F.; El Ghazali, I.; Saqrane, S.; Oufdou, K.; Vasconcelos, V.; Oudra, B. Phytotoxic effects of a natural bloom extract containing microcystins on Lycopersicon esculentum. Ecotoxicol. Environ. Saf. 2012, 79, 199–205. [Google Scholar] [CrossRef] [PubMed]
- Ainsworth, E.A.; Gillespie, K.M. Estimation of total phenolic content and other oxidation substrates in plant tissues using Folin–Ciocalteu reagent. Nat. Protoc. 2007, 2, 875–877. [Google Scholar] [CrossRef] [PubMed]
- Garg, D.; Shaikh, A.; Muley, A.; Marar, T. In vitro antioxidant activity and phytochemical analysis in extracts of Hibiscus rosa-sinensis stem and leaves. Free Radic. Antioxid. 2012, 2, 41–46. [Google Scholar] [CrossRef]
- Miranda-Arámbula, M.; Reyes-Chilpa, R.; Anaya, A.L. Phytotoxic activity of aqueous extracts of ruderal plants and its potential application to tomato crop. Bot. Sci. 2021, 99, 487–498. [Google Scholar] [CrossRef]
- Aslani, F.; Juraimi, A.S.; Ahmad-Hamdani, M.S.; Omar, D.; Alam, M.A.; Hashemi, F.S.G.; Uddin, M.K. Allelopathic effect of methanol extracts from Tinospora tuberculata on selected crops and rice weeds. Acta Agric. Scand. Sect. B–Soil Plant Sci. 2014, 64, 165–177. [Google Scholar]
- Bari, I.N.; Kato-Noguchi, H. Phytotoxic effects of Cerbera manghas L. leaf extracts on seedling elongation of four monocot and four dicot test species. Acta Agrobot. 2017, 70, 1720. [Google Scholar] [CrossRef]
- Xuan, T.D.; Tsuzuki, E.; Hiroyuki, T.; Mitsuhiro, M.; Khanh, T.D.; Chung, I.M. Evaluation on phytotoxicity of neem (Azadirachta indica. A. Juss) to crops and weeds. Crop Prot. 2004, 23, 335–345. [Google Scholar] [CrossRef]
- Khanh, T.D.; Cong, L.C.; Xuan, T.D.; Lee, S.J.; Kong, D.S.; Chung, I.M. Weed-suppressing potential of dodder (Cuscuta hygrophilae) and its phytotoxic constituents. Weed Sci. 2008, 56, 119–127. [Google Scholar] [CrossRef]
- Gonçalves, S.; Ferraz, M.; Romano, A. Phytotoxic properties of Drosophyllum lusitanicum leaf extracts and its main compound plumbagin. Sci. Hortic. 2009, 122, 96–101. [Google Scholar] [CrossRef]
- Verma, S.K.; Kumar, S.; Pandey, V.; Verma, R.K.; Patra, D.D. Phytotoxic effects of sweet basil (Ocimum basilicum L.) extracts on germination and seedling growth of commercial crop plants. Eur. J. Exp. Biol. 2012, 2, 2310–2316. [Google Scholar]
- Islam, A.K.M.M.; Kato-Noguchi, H. Inhibitory activity of medicinal plant Hyptis suaveolens: Could allelopathy be a cause? Emir. J. Food Agric. 2013, 25, 692–701. [Google Scholar] [CrossRef]
- Scott, S.J.; Jones, R.A.; Williams, W. Review of data analysis methods for seed germination. Crop Sci. 1984, 24, 1192–1199. [Google Scholar] [CrossRef]
- Esechie, H.A. Interaction of salinity and temperature on the germination of sorghum. J. Agron. Crop Sci. 1994, 172, 194–199. [Google Scholar] [CrossRef]
- Kordali, S.; Cakir, A.; Akcin, T.A.; Mete, E.; Akcin, A.; Aydin, T.; Kilic, H. Antifungal and herbicidal properties of essential oils and n-hexane extracts of Achillea gypsicola Hub-Mor. and Achillea biebersteinii Afan. (Asteraceae). Indus. Crops Prod. 2009, 29, 562–570. [Google Scholar] [CrossRef]
- Przygodzka, M.; Zielińska, D.; Ciesarová, Z.; Kukurová, K.; Zieliński, H. Comparison of methods for evaluation of the antioxidant capacity and phenolic compounds in common spices. LWT-Food Sci. Technol. 2014, 58, 321–326. [Google Scholar] [CrossRef]
- Nurcholis, W.; Putri, D.N.S.B.; Husnawati, H.; Aisyah, S.I.; Priosoeryanto, B.P. Total flavonoid content and antioxidant activity of ethanol and ethyl acetate extracts from accessions of Amomum compactum fruits. Ann. Agric. Sci. 2021, 66, 58–62. [Google Scholar] [CrossRef]
- Amir, M.; Khan, A.; Mujeeb, M.; Ahmad, A.; Usmani, S.; Akhtar, M. Phytochemical analysis and in vitro antioxidant activity of Zingiber officinale. Free Radic. Antioxid. 2011, 1, 75–81. [Google Scholar] [CrossRef]
- Konappa, N.M.; Krishnamurthy, S.; Chowdappa, S.; Siddapura, R.N. Phytochemistry and Antimicrobial Activity of Rhizome Extracts of Amomum nilgiricum from the Western Ghats, India. J. Herbs Spices Med. Plants 2019, 25, 141–157. [Google Scholar] [CrossRef]
- Konappa, N.M.; Siddaiah, C.N.; Krishnamurthy, S.; Singh, B.; Ramachandrappa, N.S. Phytochemical screening and antimicrobial activity of leaf extracts of Amomum nilgiricum (Thomas) (Zingiberaceae) from Western Ghats, India. J. Biol. Act. Prod. Nat. 2017, 7, 311–330. [Google Scholar]
- Sinitha, K.; Thoppil, J.E. Evaluation of antioxidant, anti-inflammation and chemical composition of methanolic extract of Amomum masticatorium Thwaites (Zingiberaceae). Int. J. Pharmacogn. 2017, 4, 413–418. [Google Scholar]
- Singh, H.P.; Batish, D.R.; Kaur, S.; Kohli, R.K. Phytotoxic interference of Ageratum conyzoides with wheat (Triticum aestivum). J. Agron. Crop Sci. 2003, 189, 341–346. [Google Scholar] [CrossRef]
- Scrivanti, L.R. Allelopathic potential of Bothriochloa laguroides var. laguroides (DC.) Herter (Poaceae: Andropogoneae). Flora-Morphol. Distrib. Funct. Ecol. Plants 2010, 205, 302–305. [Google Scholar] [CrossRef]
- Nourimand, M.; Mohsenzadeh, S.; Teixeira da Silva, J.A.; Saharkhiz, M.J. Allelopathic potential of fennel (Foeniculum vulgare Mill.). Med. Aromat. Plant Sci. Biotechnol. 2011, 5, 54–57. [Google Scholar]
- Poonpaiboonpipat, T.; Pangnakorn, U.; Suvunnamek, U.; Teerarak, M.; Charoenying, P.; Laosinwattana, C. Phytotoxic effects of essential oil from Cymbopogon citratus and its physiological mechanisms on barnyardgrass (Echinochloa crus-galli). Ind. Crops Prod. 2013, 41, 403–407. [Google Scholar] [CrossRef]
- Khanh, T.D.; Hong, N.H.; Xuan, T.D.; Chung, I.M. Paddy weed control by medicinal and leguminous plants from Southeast Asia. Crop Prot. 2005, 24, 421–431. [Google Scholar] [CrossRef]
- Arowosegbe, S.; Afolayan, A.J. Assessment of allelopathic properties of Aloe ferox Mill. on turnip, beetroot and carrot. Biol. Res. 2012, 45, 363–368. [Google Scholar] [CrossRef]
- Turk, M.A.; Tawaha, A.M. Allelopathic effect of black mustard (Brassica nigra L.) on germination and growth of wild oat (Avena fatua L.). Crop Prot. 2003, 22, 673–677. [Google Scholar] [CrossRef]
- Randhawa, M.A.; Cheema, Z.A.; Ali, M.A. Allelopathic effect of Sorghum Water Extract on Germination and seedling growth of Trianthema portulacastrum. Int. J. Agric. Biol. 2002, 4, 383–384. [Google Scholar]
- Batlang, U.; Shushu, D.D. Allelopathic activity of sunflower (Helianthus annuus L.) on growth and nodulation of bambara groundnut (Vigna subterranean (L.) verdc.). J. Agron. 2007, 6, 541–547. [Google Scholar]
- Ashrafi, Z.Y.; Sadeghi, S.; Alizade, H.M.; Mashhadi, H.R.; Mohamadi, E.R. Study of bioassay the allelopathical effect of Neem (Azadirachta indica) n-hexane, acetone and water-soluble extracts on six weeds. OnLine J. Biol. Sci. 2009, 1, 71–77. [Google Scholar] [CrossRef]
- Kobayashi, K. Factors affecting phytotoxic activity of allelochemicals in soil. Weed Biol. Manag. 2004, 4, 1–7. [Google Scholar] [CrossRef]
- Hanley, M.; Whiting, M. Insecticides and arable weeds: Effects on germination and seedling growth. Ecotoxicology 2005, 14, 483–490. [Google Scholar] [CrossRef] [PubMed]
- Haq, R.A.; Hussain, M.; Cheema, Z.A.; Mushtaq, M.N.; Farooq, M. Mulberry leaf water extract inhibits bermudagrass and promotes wheat growth. Weed Biol. Manag. 2010, 10, 234–240. [Google Scholar] [CrossRef]
- Islam, A.K.M.M.; Khan, M.S.I.; Kato-Noguchi, H. Allelopathic activity of Litchi chinensis Sonn. Acta Agric. Scand. Sect. B Soil Plant Sci. 2013, 63, 669–675. [Google Scholar]
- Tefera, T. Allelopathic effects of Parthenium hysterophorus extracts on seed germination and seedling growth of Eragrostis tef. J. Agron. Crop Sci. 2002, 188, 306–310. [Google Scholar] [CrossRef]

| Extract Type | Concentration mg mL−1 | Camelina | Quinoa | Cabbage | Tomato | Onion |
|---|---|---|---|---|---|---|
| Leaf | 0.10 | 100 a∗ (0.0) | 93.5 ± 0.9 bc∗ (6.5) | 75.0 ± 1.6 cde∗∗ (9.9) | 72.2 ± 4.2 ab∗∗ (3.8) | 25.0 ± 1.6 bcde∗∗ (29.0) |
| 0.15 | 99.1 ± 0.9 ab (0.9) | 92.6 ± 0.9 c (7.4) | 72.2 ± 1.6 def (13.2) | 65.7 ± 4.6 abc (12.5) | 20.4 ± 1.8 defg (42.3) | |
| 0.20 | 98.1 ± 0.9 ab (1.9) | 90.7 ± 0.9 c (9.3) | 70.4 ± 2.5 efg (15.4) | 61.1 ± 2.8 bc (18.5) | 18.5 ± 2.4 fg (47.7) | |
| Seed | 0.10 | 100 a (0.0) | 93.5 ± 0.9 bc (6.5) | 74.1 ± 0.9 cdef (11.0) | 69.4 ± 4.2 abc (7.5) | 22.2 ± 1.6 defg (37.0) |
| 0.15 | 99.1 ± 0.9 ab (0.9) | 93.5 ± 0.9 bc (6.5) | 69.4 ± 1.6 fg (16.5) | 67.6 ± 4.0 abc (10.0) | 19.4 ± 1.6 efg (44.9) | |
| 0.20 | 97.2 ± 1.6 b (2.8) | 90.7 ± 0.9 c (9.3) | 66.7 ± 3.2 g (19.8) | 57.4 ± 3.3 c (23.5) | 17.6 ± 1.8 g (50.3) | |
| Pseudo-stem | 0.10 | 100 a (0.0) | 99.1 ± 0.9 a (0.9) | 81.5 ± 0.9 ab (2.2) | 72.2 ± 4.2 ab (3.8) | 28.7 ± 1.9 bc (18.5) |
| 0.15 | 100 a (0.0) | 97.2 ± 1.6 a (2.8) | 78.7 ± 0.9 abc (5.4) | 71.3 ± 4.6 ab (5.0) | 25.9 ± 1.9 bcd (26.4) | |
| 0.20 | 100 a (0.0) | 97.2 ± 1.6 a (2.8) | 75.9 ± 0.9 cd (8.8) | 69.4 ± 4.2 abc (7.4) | 24.1 ± 2.5 cdef (31.8) | |
| Rhizome and root | 0.10 | 100 a (0.0) | 99.1 ± 0.9 a (0.9) | 82.4 ± 0.9 ab (1.1) | 74.1 ± 3.3 ab (1.2) | 30.6 ± 1.6 ab (13.2) |
| 0.15 | 100 a (0.0) | 99.1 ± 0.9 a (0.9) | 78.7 ± 0.9 abc (5.5) | 73.2 ± 4.0 ab (2.6) | 25.0 ± 1.6 bcde (29.0) | |
| 0.20 | 100 a (0.0) | 96.3 ± 1.9 ab (3.7) | 77.8 ± 0.0 bc (6.6) | 71.3 ± 3.3 ab (5.0) | 24.1 ± 2.5 cdef (31.8) | |
| Control | 100 a (0.0) | 100 a (0.0) | 83.3 ± 1.6 a (0.0) | 75.0 ± 3.2 a (0.0) | 35.2 ± 0.9 a (0.0) |
| Extract Type | Concentration mg mL−1 | Camelina | Quinoa | Cabbage | Tomato | Onion |
|---|---|---|---|---|---|---|
| Leaf | 0.10 | 2.80 ± 0.08 cde∗ | 3.80 ± 0.07 cd | 3.48 ± 0.05 bcd | 5.10 ± 0.04 bcd | 5.72 ± 0.17 cde |
| 0.15 | 2.92 ± 0.06 bcd | 3.96 ± 0.09 bc | 3.56 ± 0.03 abc | 5.18 ± 0.01 ab | 6.17 ± 0.08 ab | |
| 0.20 | 3.00 ± 0.02 ab | 4.08 ± 0.12 ab | 3.68 ± 0.08 a | 5.27 ± 0.03 a | 6.27 ± 0.17 a | |
| Seed | 0.10 | 2.78 ± 0.03 de | 3.92 ± 0.05 bc | 3.50 ± 0.07 bcd | 5.04 ± 0.02 cde | 5.74 ± 0.14 cd |
| 0.15 | 2.95 ± 0.03 bc | 4.12 ± 0.03 ab | 3.57 ± 0.06 abc | 5.12 ± 0.02 bc | 6.08 ± 0.08 abc | |
| 0.20 | 3.10 ± 0.05 a | 4.24 ± 0.07 a | 3.61 ± 0.04 ab | 5.29 ± 0.05 a | 6.42 ± 0.08 a | |
| Pseudo-stem | 0.10 | 2.56 ± 0.03 fg | 3.23 ± 0.08 f | 3.36 ± 0.04 de | 4.95 ± 0.04 ef | 5.47 ± 0.09 def |
| 0.15 | 2.74 ± 0.07 e | 3.58 ± 0.10 de | 3.43 ± 0.05 bcde | 5.02 ± 0.03 cde | 5.63 ± 0.09 def | |
| 0.20 | 2.80 ± 0.07 cde | 3.66 ± 0.12 de | 3.49 ± 0.05 bcd | 5.07 ± 0.04 bcde | 5.83 ± 0.09 bcd | |
| Rhizome and root | 0.10 | 2.48 ± 0.05 g | 3.27 ± 0.06 f | 3.28 ± 0.05 ef | 4.88 ± 0.03 f | 5.33 ± 0.07 ef |
| 0.15 | 2.57 ± 0.05 fg | 3.46 ± 0.02 ef | 3.34 ± 0.06 def | 4.96 ± 0.06 ef | 5.48 ± 0.16 def | |
| 0.20 | 2.67 ± 0.06 ef | 3.52 ± 0.01 e | 3.40 ± 0.06 cde | 4.99 ± 0.07 def | 5.68 ± 0.17 de | |
| Control | 2.04 ± 0.02 h | 2.24 ± 0.04 g | 3.18 ± 0.07 f | 4.76 ± 0.03 g | 5.26 ± 0.06 f |
| Extract Type | Concentrration mg mL−1 | Camelina | Quinoa | Cabbage | Tomato | Onion |
|---|---|---|---|---|---|---|
| Leaf | 0.10 | 15.36 ± 0.20 def∗ | 11.55 ± 0.12 e | 10.03 ± 0.06 cd | 5.56 ± 0.32 abc | 1.82 ± 0.20 cd |
| 0.15 | 14.93 ± 0.26 efg | 11.10 ± 0.03 efg | 9.64 ± 0.02 def | 5.03 ± 0.39 bcd | 1.32 ± 0.12 efg | |
| 0.20 | 14.49 ± 0.22 gh | 10.69 ± 0.13 gh | 9.24 ± 0.23 ef | 4.58 ± 0.25 cd | 1.18 ± 0.15 fg | |
| Seed | 0.10 | 15.32 ± 0.10 def | 11.31 ± 0.03 ef | 9.83 ± 0.21 de | 5.39 ± 0.34 abcd | 1.61 ± 0.14 def |
| 0.15 | 14.81 ± 0.13 fgh | 10.89 ± 0.04 fgh | 9.34 ± 0.08 ef | 5.20 ± 0.30 abcd | 1.28 ± 0.10 fg | |
| 0.20 | 14.26 ± 0.30 h | 10.34 ± 0.23 h | 8.98 ± 0.16 f | 4.37 ± 0.27 d | 1.11 ± 0.11 g | |
| Pseudo-stem | 0.10 | 16.15 ± 0.10 bc | 13.71 ± 0.13 b | 10.89 ± 0.32 ab | 5.73 ± 0.32 ab | 2.26 ± 0.11 bc |
| 0.15 | 15.68 ± 0.14 cd | 12.69 ± 0.35 d | 10.53 ± 0.14 bc | 5.54 ± 0.38 abc | 1.80 ± 0.13 cd | |
| 0.20 | 15.49 ± 0.11 de | 12.54 ± 0.44 d | 10.17 ± 0.11 cd | 5.36 ± 0.38 abcd | 1.64 ± 0.16 def | |
| Rhizome and root | 0.10 | 16.49 ± 0.17 b | 13.82 ± 0.06 b | 11.03 ± 0.34 ab | 5.93 ± 0.27 ab | 2.43 ± 0.11 ab |
| 0.15 | 16.18 ± 0.17 bc | 13.35 ± 0.07 bc | 10.54 ± 0.24 bc | 5.74 ± 0.33 ab | 1.87 ± 0.18 cd | |
| 0.20 | 15.88 ± 0.19 cd | 12.81 ± 0.29 cd | 10.33 ± 0.17 bcd | 5.61 ± 0.29 abc | 1.75 ± 0.21 de | |
| Control | 17.83 ± 0.08 a | 17.08 ± 0.10 a | 11.35 ± 0.39 a | 6.20 ± 0.18 a | 2.83 ± 0.11 a |
| Extract Type | Concentration mg mL−1 | Camelina | Quinoa | Cabbage | Tomato | Onion |
|---|---|---|---|---|---|---|
| Leaf | 0.10 | 8.4 ± 0.13 c∗ (28.2) | 10.4 ± 0.42 bcd (29.8) | 7.5 ± 0.06 bc (4.6) | 9.4 ± 0.09 b (26.2) | 22.3 ± 0.36 b (33.2) |
| 0.15 | 7.2 ± 0.11 ef (38.1) | 9.7 ± 0.17 cdef (34.5) | 7.0 ± 0.07 ef (11.2) | 8.9 ± 0.08 bc (29.9) | 15.9 ± 1.07 e (52.4) | |
| 0.20 | 7.0 ± 0.06 f (39.6) | 8.5 ± 0.09 ef (42.5) | 6.6 ± 0.05 g (15.9) | 8.2 ± 0.09 c (35.7) | 11.5 ± 1.05 f (65.7) | |
| Seed | 0.10 | 8.6 ± 0.12 c (25.9) | 9.3 ± 0.39 def (37.6) | 7.4 ± 0.13 cd (6.1) | 8.9 ± 0.04 bc (29.7) | 22.6 ± 0.03 b (32.3) |
| 0.15 | 8.4 ± 0.16 c (27.6) | 8.4 ± 0.19 ef (43.6) | 6.7 ± 0.05 fg (14.9) | 8.8 ± 0.10 bc (30.5) | 16.8 ± 0.64 de (49.8) | |
| 0.20 | 7.6 ± 0.08 de (34.8) | 8.2 ± 0.33 f (45.1) | 6.6 ± 0.19 g (16.5) | 8.0 ± 0.07 c (37.0) | 10.8 ± 0.77 f (67.7) | |
| Pseudostem | 0.10 | 9.4 ± 0.16 b (19.1) | 11.7 ± 0.67 b (20.9) | 7.8 ± 0.05 a (0.5) | 9.4 ± 0.26 b (26.2) | 31.0 ± 0.91 a (7.2) |
| 0.15 | 9.4 ± 0.08 b (19.3) | 9.7 ± 0.45 cdef (34.7) | 7.4 ± 0.08 cd (6.5) | 9.0 ± 0.07 bc (29.0) | 20.1 ± 0.74 bc (39.8) | |
| 0.20 | 8.0 ± 0.18 cd (31.1) | 9.4 ± 0.50 def (36.5) | 7.1 ± 0.08 de (10.0) | 8.9 ± 0.11 bc (29.6) | 18.5 ± 0.35 cde (44.7) | |
| Rhizome and root | 0.10 | 9.3 ± 0.10 b (20.1) | 11.1 ± 0.69 bc (25.0) | 7.8 ± 0.14 a (0.9) | 9.7 ± 0.20 b (23.3) | 22.6 ± 0.84 b (32.4) |
| 0.15 | 8.5 ± 0.14 c (27.0) | 10.0 ± 0.31 cde (32.8) | 7.2 ± 0.03 de (9.2) | 9.3 ± 0.12 b (26.5) | 19.0 ± 1.01 cd (43.1) | |
| 0.20 | 8.1 ± 0.09 c (30.1) | 9.2 ± 0.78 def (38.1) | 7.0 ± 0.11 ef (11.7) | 9.1 ± 0.10 bc (28.2) | 17.0 ± 0.82 de (49.1) | |
| Control | 11.6 ± 0.46 a (0.0) | 14.9 ± 1.03 a (0.0) | 7.9 ± 0.22 a (0.0) | 12.7 ± 1.15 a (0.0) | 33.4 ± 1.31 a (0.0) |
| Extract Type | Concentration mg mL−1 | Camelina | Quinoa | Cabbage | Tomato | Onion |
|---|---|---|---|---|---|---|
| Leaf | 0.10 | 41.4 ± 1.93 c∗ (34.4) | 14.6 ± 0.73 de∗ (44.9) | 36.8 ± 0.96 cd∗ (26.7) | 30.0 ± 0.65 ab∗ (4.8) | 12.6 ± 0.75 c∗ (39.6) |
| 0.15 | 32.2 ± 1.23 def (49.0) | 13.5 ± 0.66 e (48.9) | 35.8 ± 1.50 d (28.7) | 24.3 ± 0.53 de (22.9) | 12.3 ± 1.15 c (41.3) | |
| 0.20 | 30.6 ± 0.74 ef (51.5) | 13.0 ± 0.52 e (50.9) | 30.8 ± 1.21 e (38.6) | 22.9 ± 1.11 ef (27.2) | 7.4 ± 0.55 d (64.6) | |
| Seed | 0.10 | 44.1 ± 1.67 c (30.1) | 16.4 ± 0.37 cd (38.1) | 36.0 ± 1.29 d (28.4) | 27.5 ± 0.51 bc (12.6) | 7.3 ± 0.51 d (65.4) |
| 0.15 | 32.4 ± 0.41 de (48.7) | 14.8 ± 0.98 de (44.2) | 32.0 ± 2.15 e (36.3) | 22.8 ± 1.06 ef (27.6) | 6.5 ± 0.79 d (69.0) | |
| 0.20 | 28.5 ± 0.61 f (54.9) | 12.9 ± 0.55 e (51.1) | 30.5 ± 2.00 e (39.4) | 21.4 ± 0.82 f (32.1) | 3.4 ± 0.60 e (83.8) | |
| Pseudo-stem | 0.10 | 51.9 ± 1.82 b (17.7) | 18.5 ± 0.77 bc (30.1) | 42.6 ± 0.78 b (15.1) | 30.9 ± 1.10 a (1.9) | 18.9 ± 0.37 ab (9.6) |
| 0.15 | 41.8 ± 0.92 c (33.7) | 17.4 ± 1.29 c (34.3) | 40.1 ± 0.86 bc (20.2) | 30.5 ± 0.85 a (3.3) | 18.2 ± 0.17 b (13.1) | |
| 0.20 | 33.5 ± 0.58 de (46.9) | 14.4 ± 0.46 de (45.6) | 36.7 ± 0.66 cd (27.0) | 27.8 ± 1.21 bc (11.8) | 6.6 ± 0.21 d (68.4) | |
| Rhizome and root | 0.10 | 50.8 ± 1.16 b (19.4) | 20.3 ± 0.74 b (23.4) | 46.9 ± 1.11 a (6.6) | 31.1 ± 0.17 a (1.1) | 11.7 ± 0.93 c (44.0) |
| 0.15 | 41.5 ± 1.94 c (34.3) | 17.7 ± 0.87 c (33.1) | 37.1 ± 0.56 cd (26.2) | 26.7 ± 0.68 cd (15.2) | 10.5 ± 0.34 c (50.0) | |
| 0.20 | 35.1 ± 0.94 d (44.3) | 14.1 ± 0.72 de (46.8) | 36.3 ± 0.37 cd (27.7) | 26.5 ± 0.56 cd (15.8) | 6.2 ± 0.64 d (70.5) | |
| Control | 63.1 ± 0.46 a (0.0) | 26.5 ± 0.79 a (0.0) | 50.3 ± 0.78 a (0.0) | 31.5 ± 0.81 a (0.0) | 20.9 ± 1.32 a (0.0) |
| Extract Type | Concentration mg mL−1 | Camelina | Quinoa | Cabbage | Tomato | Onion |
|---|---|---|---|---|---|---|
| Leaf | 0.10 | 9.48 ± 0.14 bc∗ (17.4) | 8.38 ± 0.04 de (25.0) | 29.39 ± 0.42 bc (24.5) | 17.98 ± 1.21 ab (3.0) | 11.94 ± 0.66 bc (34.6) |
| 0.15 | 9.28 ± 0.11 bcd (19.2) | 8.28 ± 0.11 e (25.9) | 27.62 ± 1.34 bcde (29.1) | 15.34 ± 0.56 cd (17.2) | 9.82 ± 0.26 d (46.2) | |
| 0.20 | 8.76 ± 0.13 cde (23.7) | 8.08 ± 0.07 ef (27.7) | 23.43 ± 1.66 f (39.8) | 13.77 ± 0.64 de (25.7) | 6.52 ± 0.46 e (64.3) | |
| Seed | 0.10 | 9.47 ± 0.09 bc (17.5) | 8.39 ± 0.07 de (24.9) | 29.27 ± 0.48 bc (24.8) | 16.64 ± 0.38 abc (10.2) | 10.89 ± 0.25 cd (40.4) |
| 0.15 | 8.35 ± 0.17 de (27.3) | 7.72 ± 0.10 fg (30.9) | 24.47 ± 1.30 ef (37.1) | 14.61 ± 0.43 cde (21.2) | 9.77 ± 0.14 d (46.5) | |
| 0.20 | 7.98 ± 0.03 e (30.5) | 7.54 ± 0.18 g (32.5) | 20.05 ± 0.06 g (48.5) | 12.77 ± 0.43 e (31.1) | 6.49 ± 0.54 e (64.5) | |
| Pseudo-stem | 0.10 | 10.97 ± 0.44 a (4.4) | 9.38 ± 0.09 b (16.0) | 30.34 ± 0.37 b (22.1) | 18.53 ± 0.59 a (0.0) | 18.27 ± 0.88 a (0.0) |
| 0.15 | 9.89 ± 0.07 b (13.9) | 8.72 ± 0.03 cd (22.0) | 28.86 ± 1.17 bcd (25.9) | 16.29 ± 0.67 abc (12.1) | 12.65 ± 0.93 b (30.7) | |
| 0.20 | 9.51 ± 0.18 bc (17.2) | 8.19 ± 0.10 e (26.7) | 26.47 ± 1.25 cdef (32.0) | 15.75 ± 0.26 bcd (15.0) | 9.93 ± 0.20 d (45.6) | |
| Rhizome and root | 0.10 | 10.85 ± 0.76 a (5.5) | 9.25 ± 0.17 b (17.2) | 29.54 ± 0.70 bc (24.1) | 18.53 ± 1.22 a (0.0) | 13.47 ± 0.53 b (26.3) |
| 0.15 | 9.86 ± 0.15 b (14.1) | 8.79 ± 0.26 c (21.3) | 27.48 ± 0.29 bcde (29.4) | 18.05 ± 0.76 ab (2.6) | 10.13 ± 0.48 d (44.5) | |
| 0.20 | 9.39 ± 0.31 bc (18.2) | 8.37 ± 0.05 de (25.1) | 25.76 ± 1.79 def (33.8) | 16.79 ± 0.90 abc (9.4) | 9.22 ± 0.10 d (49.5) | |
| Control | 11.48 ± 0.58 a (0.0) | 11.17 ± 0.15 a (0.0) | 38.93 ± 0.81 a (0.0) | 18.53 ± 0.52 a (0.0) | 18.27 ± 0.67 a (0.0) |
| Extract Type | Concentration mg mL−1 | Camelina | Quinoa | Cabbage | Tomato | Onion |
|---|---|---|---|---|---|---|
| Leaf | 0.10 | 1.33 ± 0.04 b∗ (24.2) | 1.63 ± 0.07 a (3.0) | 4.02 ± 0.08 cd (19.5) | 1.76 ± 0.03 ab (5.7) | 1.64 ± 0.12 abc (16.1) |
| 0.15 | 1.31 ± 0.08 b (25.0) | 1.60 ± 0.01 a (4.8) | 3.91 ± 0.07 cd (21.8) | 1.64 ± 0.07 ab (12.2) | 1.28 ± 0.09 cde (34.5) | |
| 0.20 | 1.27 ± 0.02 b (27.4) | 1.45 ± 0.06 a (14.1) | 3.38 ± 0.17 f (32.2) | 1.59 ± 0.10 ab (14.8) | 1.16 ± 0.20 de (40.7) | |
| Seed | 0.10 | 1.32 ± 0.03 b (24.4) | 1.62 ± 0.11 a (3.6) | 3.89 ± 0.13 cd (22.0) | 1.75 ± 0.06 ab (5.9) | 1.56 ± 0.12 abcd (19.8) |
| 0.15 | 1.28 ± 0.08 b (26.9) | 1.57 ± 0.10 a (6.9) | 3.44 ± 0.04 f (31.2) | 1.61 ± 0.06 ab (13.6) | 1.22 ± 0.02 cde (37.4) | |
| 0.20 | 1.22 ± 0.06 b (30.3) | 1.44 ± 0.08 a (14.3) | 3.37 ± 0.10 f (32.5) | 1.55 ± 0.06 b (17.0) | 1.12 ± 0.15 e (42.6) | |
| Pseudo-stem | 0.10 | 1.37 ± 0.04 b (21.7) | 1.68 ± 0.11 a (0.4) | 4.37 ± 0.10 b (12.5) | 1.82 ± 0.04 ab (2.3) | 1.95 ± 0.23 a (0.2) |
| 0.15 | 1.34 ± 0.06 b (23.2) | 1.64 ± 0.05 a (2.6) | 3.96 ± 0.09 cd (20.8) | 1.71 ± 0.17 ab (8.1) | 1.52 ± 0.12 bcde (22.2) | |
| 0.20 | 1.31 ± 0.06 b (25.3) | 1.62 ± 0.12 a (3.6) | 3.76 ± 0.08 de (24.7) | 1.63 ± 0.02 ab (12.5) | 1.30 ± 0.06 cde (33.3) | |
| Rhizome and root | 0.10 | 1.36 ± 0.03 b (22.5) | 1.68 ± 0.12 a (0.4) | 4.18 ± 0.08 bc (16.2) | 1.86 ± 0.05 a (0.4) | 1.87 ± 0.13 ab (4.1) |
| 0.15 | 1.33 ± 0.07 b (24.2) | 1.66 ± 0.08 a (1.4) | 3.94 ± 0.17 cd (21.1) | 1.78 ± 0.15 ab (4.7) | 1.48 ± 0.09 bcde (24.3) | |
| 0.20 | 1.29 ± 0.05 b (26.3) | 1.65 ± 0.04 a (2.0) | 3.51 ± 0.05 ef (29.8) | 1.68 ± 0.07 ab (10.0) | 1.32 ± 0.05 cde (32.3) | |
| Control | 1.75 ± 0.06 a (0.0) | 1.68 ± 0.08 a (0.0) | 4.99 ± 0.09 a (0.0) | 1.86 ± 0.07 a (0.0) | 1.95 ± 0.06 a (0.0) |
Disclaimer/Publisher’s Note: The statements, opinions and data contained in all publications are solely those of the individual author(s) and contributor(s) and not of MDPI and/or the editor(s). MDPI and/or the editor(s) disclaim responsibility for any injury to people or property resulting from any ideas, methods, instructions or products referred to in the content. |
© 2023 by the authors. Licensee MDPI, Basel, Switzerland. This article is an open access article distributed under the terms and conditions of the Creative Commons Attribution (CC BY) license (https://creativecommons.org/licenses/by/4.0/).
Share and Cite
Khuat, Q.V.; Kalashnikova, E.A.; Nguyen, H.T.; Trukhachev, V.I.; Kirakosyan, R.N. In Vitro Effect of Purple Amomum (Amomum longiligulare T.L. Wu) Extracts on Seed Germination and Seedling Growth of Different Crop Species. Horticulturae 2023, 9, 554. https://doi.org/10.3390/horticulturae9050554
Khuat QV, Kalashnikova EA, Nguyen HT, Trukhachev VI, Kirakosyan RN. In Vitro Effect of Purple Amomum (Amomum longiligulare T.L. Wu) Extracts on Seed Germination and Seedling Growth of Different Crop Species. Horticulturae. 2023; 9(5):554. https://doi.org/10.3390/horticulturae9050554
Chicago/Turabian StyleKhuat, Quyet V., Elena A. Kalashnikova, Hai T. Nguyen, Vladimir I. Trukhachev, and Rima N. Kirakosyan. 2023. "In Vitro Effect of Purple Amomum (Amomum longiligulare T.L. Wu) Extracts on Seed Germination and Seedling Growth of Different Crop Species" Horticulturae 9, no. 5: 554. https://doi.org/10.3390/horticulturae9050554
APA StyleKhuat, Q. V., Kalashnikova, E. A., Nguyen, H. T., Trukhachev, V. I., & Kirakosyan, R. N. (2023). In Vitro Effect of Purple Amomum (Amomum longiligulare T.L. Wu) Extracts on Seed Germination and Seedling Growth of Different Crop Species. Horticulturae, 9(5), 554. https://doi.org/10.3390/horticulturae9050554

